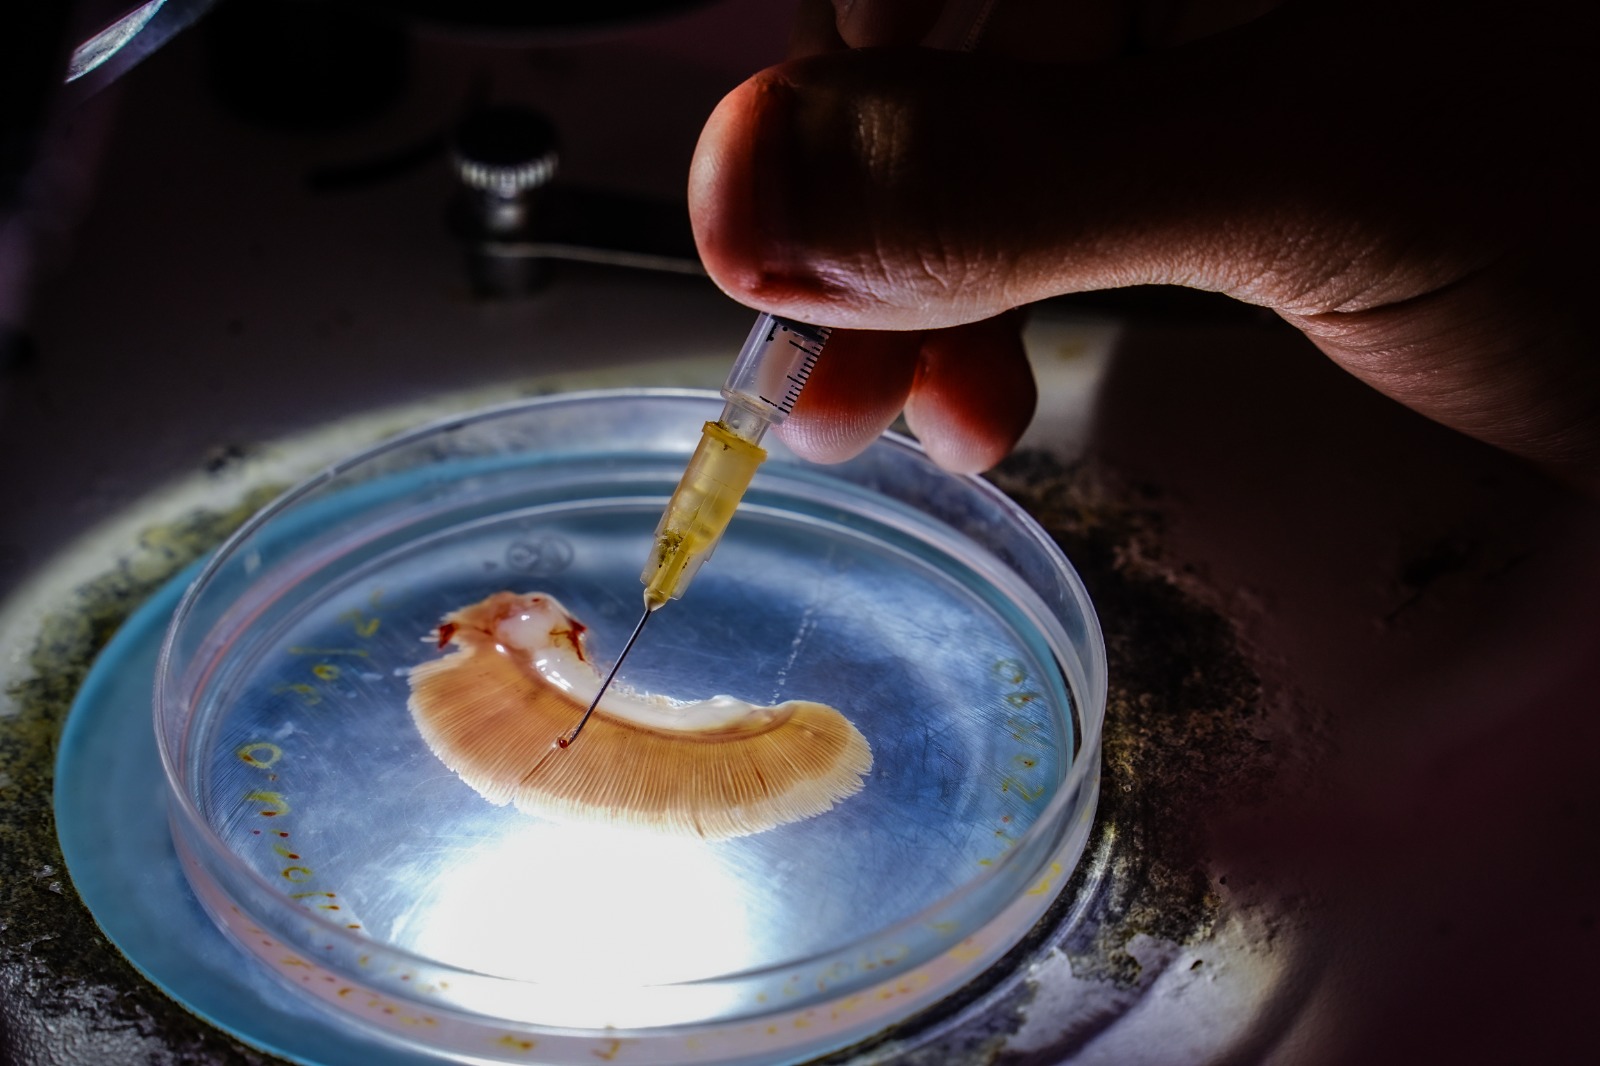

Comunicación Social
Mazatlán, Sin.- El Gobierno de Mazatlán y el Instituto de Cultura, Turismo y Arte, en conjunto con la comunidad científica, invitan a la séptima edición del exitoso programa de divulgación “La Ciencia también es Cultura”. Este jueves 6 de noviembre, a las cinco de la tarde, en la Casa del Marino, el tema central será el fascinante y relevante universo de los “Parásitos”, organismos que tienen un impacto directo en la economía, la salud humana y el medio ambiente.
El evento contará con la participación de destacados investigadores de la Facultad de Ciencias del Mar de la Universidad Autónoma de Sinaloa (UAS): Dra. Mayra Ixechel Grano Maldonado, Investigadora experta en parasitología acuática; Doctorante, Gibrian López Ceseña; Estudiante de Maestría, María Guadalupe Zambrano Sandoval.

La importancia de los Parásitos
La Dra. Mayra Grano Maldonado compartirá una perspectiva que desafía la creencia popular. Lejos de ser siempre «malos o grotescos», los parásitos son piezas clave en la naturaleza:
«Son bioindicadores de contaminación y bioindicadores de la salud de los ecosistemas. Si hay parásitos, quiere decir que el sistema es tan limpio que el sistema funciona… Cuando no hay parásitos, no es tan bueno», expresó la especialista, al añadir que su presencia es una señal de que los ciclos de vida y el flujo de masa se están completando correctamente en el océano o en un cultivo.
Amenaza y prevención en la acuacultura local
En el sector de la acuacultura, que en Sinaloa ha superado a la pesca en algunas especies comerciales, los parásitos representan una seria amenaza económica.
El Doctorante Gibrian López Ceseña presentará su trabajo sobre los parásitos de la Bahía de Mazatlán y las investigaciones desarrolladas en torno a las mortalidades en sistemas acuícolas.
«Si hay maneras de prevenirlo y una de ellas es la calidad del agua. Si se mantiene una buena calidad de agua, es muy probable que no pueda haber infecciones parasitarias, sin embargo, Sinaloa tiene un pequeño detalle que son las altas temperaturas,» comentó López Ceseña.

Parásitos Digenios: Un riesgo para el humano
Por su parte, la estudiante Guadalupe Zambrano Sandoval compartirá los avances de su investigación sobre los parásitos digenios, gusanos aplanados cuyo ciclo de vida involucra a los moluscos como primeros hospederos intermediarios. Este tipo de organismos ha afectado al ser humano, con casos registrados especialmente en países como Japón y Corea.
¡No pierda esta oportunidad de conocer y comprender la vida oculta que nos rodea! Asista este jueves a Casa del Marino y sumérjase en el increíble mundo de los parásitos. La entrada es gratuita.